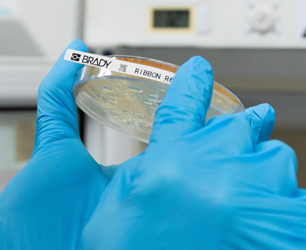
Inteligentne oznaczanie RFID Brady - od etykiety do gotowego systemu

Technologia RFID przestała być ciekawostką - stała się fundamentem nowoczesnego zarządzania majątkiem, logistyką i sprzedażą. Brady, jako producent kompletnego systemu RFID, łączy etykiety, drukarki, czytniki oraz oprogramowanie w spójne rozwiązanie, które pozwala nadać dla każdego aktywu unikatową tożsamość cyfrową i śledzić je w czasie rzeczywistym.
Sprawdź, jak wygląda oznaczanie RFID w wykonaniu Brady i jakie korzyści może dać Twojej firmie.
Czym jest oznaczanie RFID i dlaczego właśnie Brady?
RFID (Radio Frequency Identification) to technologia identyfikacji radiowej, w której do obiektu mocowana jest etykieta z układem scalonym i anteną. Dane z takiej etykiety można odczytać automatycznie, bez widoczności optycznej i z wielu metrów - w przypadku UHF nawet do około 15 m, a w ciągu jednej sekundy możliwy jest odczyt ponad 1000 etykiet.
Brady oferuje kompletny system RFID obejmujący:
- pasywne etykiety RFID (bez baterii),
- drukarki RFID i zestawy startowe,
- czytniki ręczne i stacjonarne,
- oprogramowanie i platformę IoT Nordic ID Technology by Brady.
Dzięki temu jedna marka może obsłużyć cały proces - od zaprojektowania etykiety po integrację danych z systemami ERP, WMS, MES czy systemami sprzedażowymi.
Ekosystem oznaczania RFID Brady
1. Etykiety RFID - podstawa inteligentnego oznaczania
Etykiety RFID Brady wyposażone są w chip i antenę, a jednocześnie zachowują wszystkie cechy profesjonalnych materiałów identyfikacyjnych: odporność na temperaturę, chemikalia, ścieranie czy promieniowanie UV, możliwość pracy na metalu, plastiku, szkle, kartonie czy drewnie.
W ofercie znajdziemy m.in.:
- etykiety RFID do powierzchni metalowych,
- etykiety do zastosowań laboratoryjnych,
- etykiety o podwójnej częstotliwości (HF/UHF),
- etykiety i przywieszki do kabli i przewodów,
- etykiety klasy przemysłowej do pracy w terenie.
Każdy zasób oznaczony taką etykietą staje się „czytelny” dla systemów zgodnych z koncepcją IoT i Przemysłu 4.0 - w czasie rzeczywistym widać, gdzie się znajduje i jaki ma status.
2. Etykiety LED RFID - pick-to-light bez baterii
Szczególnie ciekawą innowacją Brady są etykiety LED RFID, które łączą oznaczenie RFID z diodą LED.
- Etykiety są bezbateryjne - energię czerpią z pola czytnika RFID.
- Można je odczytać z dystansu do około 15 m, a dioda LED aktywuje się automatycznie, gdy operator zbliży się na około 3,5 m.
- Dostępne są wersje do komponentów i regałów oraz etykiety z flagą do kabli.
- Zakres temperatur pracy sięga od -40°C do 85°C, a materiały (poliester, polipropylen) są przystosowane do powierzchni niemetalowych, takich jak karton, plastik czy szkło.
Pozwala to wdrożyć koncepcję pick-to-light w magazynach, e-commerce, produkcji czy centrach danych - operator skanuje zadanie, system „podświetla” właściwe miejsce, a ryzyko błędu kompletacyjnego maleje.
3. Drukarki i zestawy RFID - druk i kodowanie w jednym kroku
Drukarka RFID łączy funkcję tradycyjnej drukarki etykiet z modułem kodowania RFID - w jednym przebiegu zadrukowuje etykietę (np. tekst, logo, kod kreskowy) i zapisuje dane w chipie.

Brady oferuje:
- dedykowane drukarki RFID dla różnych wolumenów druku - od rozwiązań biurkowych po przemysłowe,
- zestawy RFID z drukarką, materiałem etykietowym i oprogramowaniem, umożliwiające szybki start w oznaczaniu kabli i aktywów.
Dzięki temu firma może samodzielnie drukować i kodować etykiety w miejscu użycia, bez konieczności zamawiania gotowych oznaczeń z zewnątrz.
4. Czytniki RFID - od inwentaryzacji po precyzyjne namierzanie
Brady rozwija zarówno czytniki stacjonarne (np. do bram, tuneli, stanowisk kontrolnych), jak i urządzenia mobilne, takie jak EXA81 i HH86.
- EXA81 - lekki moduł skanera z uchwytem pistoletowym i mocowaniem na smartfon lub tablet. Umożliwia odczyt ponad 1000 etykiet na sekundę w promieniu do 15 m, łączność Bluetooth 5.3 lub USB-C oraz pracę przez 24 godziny na jednym ładowaniu.
- HH86 - ręczny czytnik-komputer z systemem Android 13, obsługujący RFID HF i UHF, kody 1D/2D oraz NFC. Kołowa polaryzacja anteny umożliwia szybki odczyt niezależnie od położenia etykiety (do 1200 etykiet na sekundę i zasięg do 10 m), a akumulator zapewnia pracę nawet do 18 godzin. Urządzenie ma klasę IP65 i łączność Wi-Fi, 4G, Bluetooth 5.1.
W praktyce oznacza to możliwość szybkiej inwentaryzacji, lokalizacji krytycznych zasobów czy namierzania pojedynczego produktu w gęsto zabudowanym magazynie.

Praktyczne zastosowania oznaczania RFID Brady
Magazyn i logistyka - pełna widoczność przepływu towarów
W magazynach technologia RFID Brady pozwala:
- śledzić palety i kartony na każdym etapie łańcucha dostaw,
- automatycznie rejestrować przyjęcia i wydania towaru przy bramach i w tunelach RFID,
- skrócić czas rozładunku dostaw - etykiety są odczytywane „hurtem” przy przejeździe przez bramkę,
- szybko zlokalizować konkretny produkt na półce za pomocą czytnika mobilnego i/lub etykiet LED RFID.
System RFID znakomicie sprawdza się w takich zadaniach jak zarządzanie aktywami, inwentaryzacja, śledzenie przesyłek, sterowanie produkcją czy rozliczanie opakowań zwrotnych, co przekłada się na oszczędność czasu i redukcję błędów ludzkich.
Produkcja - od kontroli jakości po automatyczne listy kompletacyjne
Oznaczenie komponentów RFID daje możliwość:
- weryfikacji, czy dana paleta lub karton zawiera właściwą zawartość,
- śledzenia elementów na liniach montażowych,
- automatyzacji list kompletacyjnych - system porównuje odczytane etykiety z listą z ERP i sygnalizuje braki lub pomyłki,
- dokumentowania trasy produktu dla wymogów jakościowych i audytów.
RFID w połączeniu z drukarkami i aplikatorami etykiet pozwala także zautomatyzować proces znakowania - kodowanie etykiety, weryfikacja poprawności i nadruk odbywają się w jednym cyklu, co znacząco podnosi wydajność linii i eliminuje koszt błędnych etykiet.
Handel detaliczny - odpowiedź na najważniejsze wyzwania
Branża retail szczególnie korzysta z pełnej widoczności zapasów w czasie rzeczywistym. System RFID pomaga rozwiązać m.in.:

- całodobowe śledzenie produktów w całym łańcuchu dostaw,
- obsługę dużych wolumenów bez ręcznego liczenia,
- ograniczanie strat (kradzieże, zagubienia),
- przyspieszenie procesów przyjęć i wydań,
- automatyczne potwierdzanie dostaw i kompletacji,
- obsługę zwrotów,
- niedobór pracowników - jedna osoba może wykonać pracę wielu dzięki automatyzacji,
- integrację danych RFID z systemami ERP/CRM.
Oznaczenie każdego produktu lub palety etykietą RFID umożliwia zarządzanie zapasami w czasie rzeczywistym - czytniki w strefach przyjęć i składowania automatycznie zbierają dane o stanach magazynowych.
IT, centra danych i infrastruktura - szybkie namierzanie kabli
Etykiety z flagą LED RFID Brady idealnie wpisują się w potrzeby centrów danych, infrastruktury telekomunikacyjnej i instalacji budynkowych:
- przy gęstym okablowaniu łatwo „podświetlić” konkretny przewód,
- pracownik serwisu sprawniej lokalizuje przewód do zmiany lub testu,
- czas przestojów i ryzyko omyłkowego odłączenia niewłaściwego kabla znacząco spada.
Najważniejsze korzyści z oznaczania RFID
1. Pełna widoczność aktywów
Każdy zasób z etykietą RFID staje się elementem „Internetu Rzeczy” - można go błyskawicznie zidentyfikować, zlokalizować i powiązać z dodatkowymi danymi (numer serii, klient, termin ważności itd.).
2. Redukcja błędów i strat
Automatyczny odczyt tysięcy etykiet w sekundę minimalizuje ryzyko pomyłek związanych z ręcznym skanowaniem kodów czy przepisywaniem danych. Rozwiązania RFID w punktach wejścia/wyjścia ograniczają też straty wynikające z nieautoryzowanego wynoszenia towaru.
3. Oszczędność czasu i pracy ludzkiej
Inwentaryzacja, która wcześniej zajmowała godziny lub dni, z RFID trwa minuty, a wiele zadań może wykonać jedna osoba.
4. Skalowalność i łatwa integracja
Nowoczesne rozwiązania RFID Brady są projektowane tak, aby łatwo integrowały się z istniejącym środowiskiem IT - systemami ERP, WMS, MES czy platformami analitycznymi.
Jak przygotować się do wdrożenia RFID?
- Analiza procesów - identyfikacja miejsc, gdzie tracony jest czas lub pojawia się najwięcej błędów (inwentaryzacja, kompletacja, przyjęcia, zwroty).
- Dobór etykiet RFID - określenie rodzaju powierzchni (metal, plastik, szkło), warunków środowiskowych, wymaganej żywotności i zasięgu odczytu.
- Wybór drukarki RFID - skala dziennych wydruków, rodzaj materiału etykietowego i potrzeba mobilności.
- Dobór czytników i anten - czy potrzebne są bramki/tunele, czy wystarczą czytniki ręczne (EXA81, HH86) do inwentaryzacji i lokalnego namierzania.
- Integracja z systemami - zaprojektowanie przepływu danych pomiędzy oprogramowaniem RFID Brady a istniejącymi systemami biznesowymi.
- Pilotaż i skalowanie - start na jednym procesie lub lokalizacji, a następnie stopniowe rozszerzanie zakresu oznaczania.

FAQ - najczęściej zadawane pytania o oznaczanie RFID Brady
1. Czy wdrożenie RFID oznacza konieczność wymiany wszystkich dotychczasowych etykiet i systemów IT?
Nie zawsze. RFID można wdrażać etapami - najpierw na wybranych procesach (np. inwentaryzacja, kompletacja, śledzenie palet), równolegle korzystając z dotychczasowych kodów kreskowych czy oznaczeń drukowanych. Rozwiązania Brady są projektowane tak, aby integrowały się z istniejącymi systemami ERP, WMS czy MES, dzięki czemu nie trzeba zmieniać całej infrastruktury IT - zamiast tego stopniowo rozszerza się zakres oznaczania RFID.
2. W jakich warunkach środowiskowych można stosować etykiety RFID Brady?
Brady oferuje szeroką gamę specjalistycznych materiałów - od etykiet odpornych na wysokie i niskie temperatury, przez odporne na chemikalia, ścieranie i promieniowanie UV, aż po rozwiązania na metal, szkło czy plastik. Dostępne są również etykiety LED RFID z zakresem pracy od około -40°C do 85°C, co pozwala stosować je zarówno w magazynach i zakładach produkcyjnych, jak i w trudniejszych warunkach terenowych czy technicznych.
3. Jaka jest różnica między zwykłą etykietą RFID a etykietą LED RFID Brady?
Klasyczna etykieta RFID umożliwia zdalny odczyt i zapis danych z użyciem czytnika - obiekt staje się widoczny w systemie, ale sama etykieta „nic nie pokazuje”.
Etykieta LED RFID Brady łączy funkcję oznaczenia RFID z diodą LED, która może być zdalnie aktywowana. Dzięki temu nie tylko wiemy, że dana etykieta jest w zasięgu, ale możemy też wizualnie wskazać właściwy produkt, karton, półkę czy kabel (np. w koncepcji pick-to-light), co znacząco przyspiesza pracę i ogranicza liczbę pomyłek operatorów.
Podsumowanie
Oznaczanie RFID w standardzie Brady to nie tylko kolejny rodzaj etykiety, ale kompletny system budujący inteligentne, odporne na błędy środowisko pracy.
Połączenie specjalistycznych etykiet (w tym LED RFID), drukarek i zestawów kodujących, zaawansowanych czytników mobilnych i stacjonarnych oraz platformy oprogramowania RFID sprawia, że każda firma - od magazynu i zakładu produkcyjnego po sieć retail czy centrum danych - może szybko przejść od klasycznego znakowania do w pełni cyfrowej identyfikacji aktywów.
Jeśli w Twojej organizacji męczące są inwentaryzacje, problematyczne śledzenie przesyłek, kompletacja czy zarządzanie majątkiem, oznaczanie RFID Brady jest naturalnym kolejnym krokiem w kierunku automatyzacji i Przemysłu 4.0.
Grupa ASTAT, jako Złoty Dystrybutor Brady w Polsce, wspiera firmy na każdym etapie tego procesu - od doboru odpowiednich etykiet, drukarek i czytników RFID, przez testy i pilotaże, aż po pełne wdrożenie i szkolenia użytkowników.
Dzięki ponad 30-letniemu doświadczeniu w obszarze automatyki przemysłowej i kompleksowej ofercie komponentów dla przemysłu, energetyki i infrastruktury, ASTAT zapewnia nie tylko dostęp do najnowszych rozwiązań Brady, ale także fachowe doradztwo i szybką realizację dostaw, pomagając realnie zwiększać efektywność i bezpieczeństwo procesów w przedsiębiorstwach.